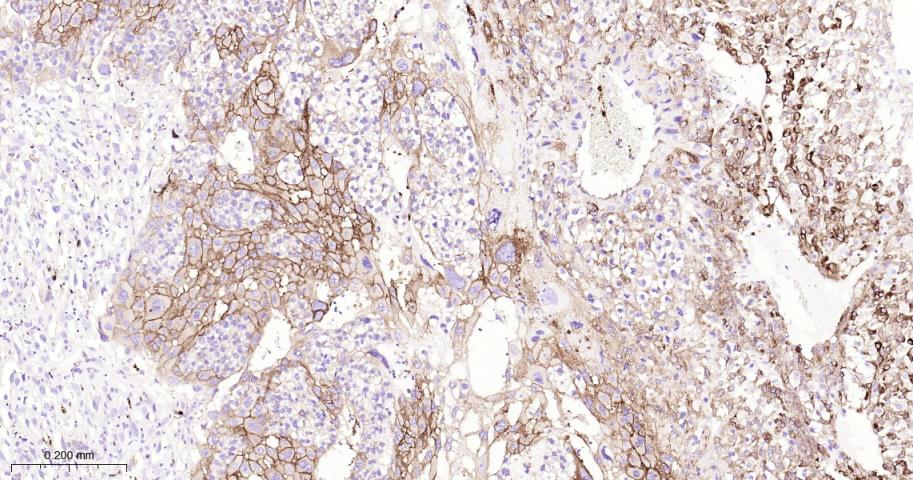
ITGB3 Recombinant Rabbit mAb(b

相关产品推荐更多 >

Histone H4 Rabbit pAb, Cy5 conjugated(bs-23810R-Cy5)-100ul
¥2980
Nur77 Rabbit pAb, Cy5.5 conjugated(bs-3513R-Cy5.5)-100ul
¥2980
PROK2 Rabbit pAb(bs-5784R)-50ul/100ul/200ul
¥1180
Metallothionein 3 Rabbit pAb, Cy3 conjugated(bs-4940R-Cy3)-100ul
¥2980
phospho-MAP3K8 (Ser400) Rabbit pAb, HRP conjugated(bs-3454R-HRP)-100ul
¥2980
万千商家帮你免费找货
0 人在求购买到急需产品
- 详细信息
- 技术资料
- 应用范围:
产品信息以Bioss网站为准
- 规格:
50ul/100ul
| 规格: | 50ul | 产品价格: | ¥1400.0 |
|---|---|---|---|
| 规格: | 100ul | 产品价格: | ¥2500.0 |
| 产品编号 | bsm-52374R |
| 英文名称 | ITGB3 Recombinant Rabbit mAb |
| 中文名称 | 整合素β3/CD61重组兔单抗 |
| 英文别名 | Integrin beta-3; Integrin beta chain, β3 precursor; Integrin beta 3; CD 61; CD61; CD61 antigen; GP3A; GPIIIa; HPA 1; HPA 4; Integrin beta 3(platelet glycoprotein IIIa antigen CD61); Integrin beta chain beta 3; ITG B3; ITGB 3; NAIT; Platelet fibrinogen receptor beta subunit; Platelet glycoprotein IIIa; platelet glycoprotein IIIa precursor; Platelet membrane glycoprotein IIIa; PTP; ITB3_HUMAN. |
| 中文别名 | Integrin β3; Integrin-β3; Integrin β 3; Integrinβ3; |
| 产品应用 | WB=1:500-2000, IHC-P=1:100-500, IHC-F=1:100-500, IF=1:100-500 Not yet tested in other applications. |
| 交叉反应 | Human, Mouse, Rat |
| 抗体来源 | Rabbit |
| 免疫原 | A synthesized peptide derived from human Integrin beta 3 |
| 亚型 | IgG |
| 性状 | Liquid |
| 纯化方法 | affinity purified by Protein A |
| 克隆类型 | Recombinant |
| 理论分子量 | 84 kDa |
| 浓度 | 1mg/ml |
| 储存液 | 0.01M TBS (pH7.4) with 1% BSA, 0.02% Proclin300 and 50% Glycerol. |
| 研究领域 | Epigenetics and Nuclear Signaling > Cell cycle > Chromosome Structure > Centromere Epigenetics and Nuclear Signaling > Chromosome Structure > Centromeres Epigenetics and Nuclear Signaling > Nuclear Signaling Pathways > NFkB pathway Epigenetics and Nuclear Signaling > Nuclear Signaling Pathways > Nuclear Receptors > Co-activators/co-repressors Signal Transduction > Cytoskeleton / ECM > Cell Adhesion > Integrins > Beta Signal Transduction > Signaling Pathway > Nuclear Signaling > NFkB Pathway Signal Transduction > Signaling Pathway > Nuclear Signaling > Nuclear Hormone Receptors > Co-activators/co-repressors |
| 亚基 | Heterodimer of an alpha and a beta subunit. Beta-3 associates with either alpha-IIb or alpha-V. Isoform Beta-3C interacts with FLNB. Interacts with COMP. Interacts with HIV-1 Tat. Interacts with PDIA6 following platelet stimulation. Interacts with SYK; upon activation by ITGB3 promotes platelet adhesion. Interacts with MYO10. |
| 亚细胞定位 | Membrane; Single-pass type I membrane protein. |
| 组织特异性 | Isoform beta-3A and isoform beta-3C are widely expressed. Isoform beta-3A is specifically expressed in osteoblast cells; isoform beta-3C is specifically expressed in prostate and testis. |
| 翻译后修饰 | Phosphorylated on tyrosine residues in response to thrombin-induced platelet aggregation. Probably involved in outside-in signaling. A peptide (AA 740-762) is capable of binding GRB2 only when both Tyr-773 and Tyr-785 are phosphorylated. Phosphorylation of Thr-779 inhibits SHC binding. |
| 相似性 | Belongs to the integrin beta chain family. Contains 1 VWFA domain. |
| 功能 | Integrin alpha-V/beta-3 is a receptor for cytotactin, fibronectin, laminin, matrix metalloproteinase-2, osteopontin, osteomodulin, prothrombin, thrombospondin, vitronectin and von Willebrand factor. Integrin alpha-IIb/beta-3 is a receptor for fibronectin, fibrinogen, plasminogen, prothrombin, thrombospondin and vitronectin. Integrins alpha-IIb/beta-3 and alpha-V/beta-3 recognize the sequence R-G-D in a wide array of ligands. Integrin alpha-IIb/beta-3 recognizes the sequence H-H-L-G-G-G-A-K-Q-A-G-D-V in fibrinogen gamma chain. Following activation integrin alpha-IIb/beta-3 brings about platelet/platelet interaction through binding of soluble fibrinogen. This step leads to rapid platelet aggregation which physically plugs ruptured endothelial surface. In case of HIV-1 infection, the interaction with extracellular viral Tat protein seems to enhance angiogenesis in Kaposi's sarcoma lesions. |
| 保存条件 | Shipped at 4℃. Store at -20℃ for one year. Avoid repeated freeze/thaw cycles. |
| 注意事项 | This product as supplied is intended for research use only, not for use in human, therapeutic or diagnostic applications. |
| 背景资料 | The ITGB3 protein product is the integrin beta chain beta 3. Integrins are integral cell-surface proteins composed of an alpha chain and a beta chain. A given chain may combine with multiple partners resulting in different integrins. Integrin beta 3 is found along with the alpha IIb chain in platelets. Integrins are known to participate in cell adhesion as well as cell-surface mediated signalling. [provided by RefSeq, Jul 2008] |
| 应用 | 推荐稀释比例 |
| {WB} | {1:500-2000} |
| {IHC-P} | {1:100-500} |
| {IHC-F} | {1:100-500} |
| {IF} | {1:100-500} |

风险提示:丁香通仅作为第三方平台,为商家信息发布提供平台空间。用户咨询产品时请注意保护个人信息及财产安全,合理判断,谨慎选购商品,商家和用户对交易行为负责。对于医疗器械类产品,请先查证核实企业经营资质和医疗器械产品注册证情况。
技术资料暂无技术资料 索取技术资料





